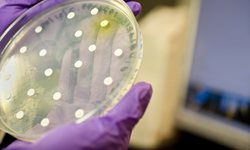

![]() Corbis
Corbis
El tejido adiposo marrón de los roedores –también en humanos– se ve afectado por el aumento a la exposición de la luz artificial, según un estudio.
![]()
En caso de salir adelante, el proyecto de Google deberá encontrar un encaje en el actual código de circulación.
![]()
Estos estudios se podrían usar en la coordinación de pequeños robots para limpiar áreas contaminadas.
![]() Puesta de sol desde Marte | NASA
Puesta de sol desde Marte | NASA
Entre dos tormentas de polvo, la sonda Curiosity de la NASA captó las imágenes de una azulada puesta de Sol desde la superficie de Marte.
En Europa y en EE UU afloran iniciativas para que los niños aprendan ya en la escuela esta destreza cada vez más indispensable.
![]() | Flickr/CC/Ray Franco Bouly
| Flickr/CC/Ray Franco Bouly
l algoritmo automático de Facebook utiliza un gran número de variables para dar preferencia a contenidos que considera que el usuario quiere ver.
![]() | Aferro
| Aferro
Quo
Los investigadores consiguieron esta supertela rociando a los artrópodos con grafeno.
![]()
El acuerdo permitirá incluir atracciones y espectáculos basados en títulos de Nintendo.
![]() Una de las fotografías más conocidas de Einstein. | Corbis
Una de las fotografías más conocidas de Einstein. | Corbis
Juan Manuel Sabugo
En su adolescencia, Einstein se hizo una pregunta cuya respuesta cambiaría la física para siempre.
Un informe revela cómo el Gobierno marroquí hostiga a las organizaciones críticas.